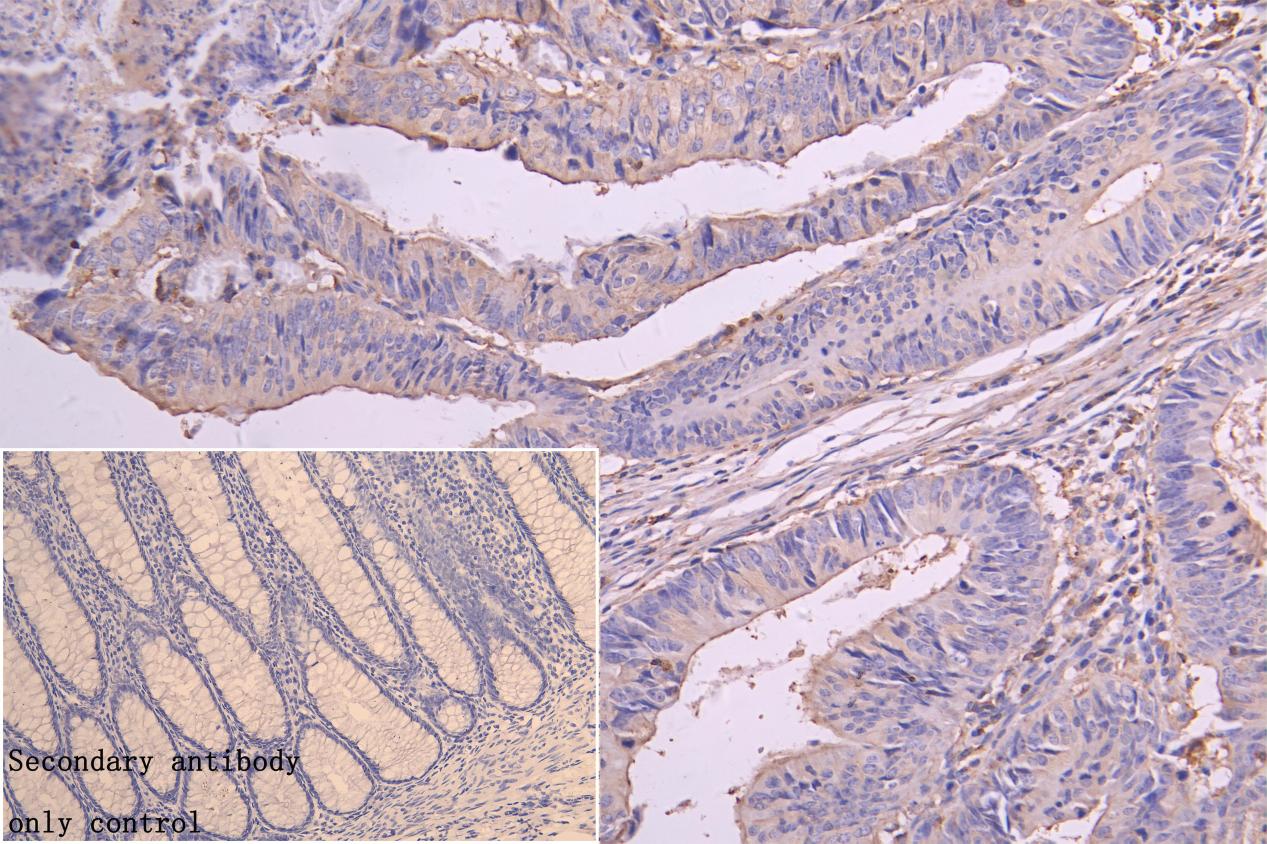

LANCL1 Antibody
-
中文名稱:LANCL1兔多克隆抗體
-
貨號:CSB-PA012742LA01HU
-
規(guī)格:¥440
-
圖片:
-
Western Blot
Positive WB detected in: Mouse Brain tissue lysate, Mouse Kidney tissue lysate, Mouse skeletal muscle tissue lysate, Mous Liver tissue lysate, Rat Kidney tissue lysate, Rat Heart tissue lysate, A549 whole cell lysate, Hela whole cell lysate, HepG2 whole cell lysate
All lanes: LANCL1 antibody at 1:1000
Secondary
Goat polyclonal to rabbit IgG at 1/50000 dilution
Predicted band size: 42 kDa
Observed band size: 42 kDa -
IHC image of CSB-PA012742LA01HU diluted at 1:300 and staining in paraffin-embedded human testis tissue performed on a Leica BondTM system. After dewaxing and hydration, antigen retrieval was mediated by high pressure in a citrate buffer (pH 6.0). Section was blocked with 10% normal goat serum 30min at RT. Then primary antibody (1% BSA) was incubated at 4°C overnight. The primary is detected by a Goat anti-rabbit polymer IgG labeled by HRP and visualized using 0.05% DAB. Secondary antibody only control: uses 1% BSA instead of primary antibody
-
IHC image of CSB-PA012742LA01HU diluted at 1:300 and staining in paraffin-embedded human colorectal cancer performed on a Leica BondTM system. After dewaxing and hydration, antigen retrieval was mediated by high pressure in a citrate buffer (pH 6.0). Section was blocked with 10% normal goat serum 30min at RT. Then primary antibody (1% BSA) was incubated at 4°C overnight. The primary is detected by a Goat anti-rabbit polymer IgG labeled by HRP and visualized using 0.05% DAB. Secondary antibody only control: uses 1% BSA instead of primary antibody
-
-
其他:
產(chǎn)品詳情
-
產(chǎn)品名稱:Rabbit anti-Homo sapiens (Human) LANCL1 Polyclonal antibody
-
Uniprot No.:
-
基因名:LANCL1
-
別名:40 kDa erythrocyte membrane protein antibody; G protein-coupled receptor 69A antibody; GPR69A antibody; LanC (bacterial lantibiotic synthetase component C) like 1 antibody; LanC lantibiotic synthetase component C like 1 (bacterial) antibody; LanC-like protein 1 antibody; LANC1_HUMAN antibody; LANCL1 antibody; p40 antibody
-
宿主:Rabbit
-
反應(yīng)種屬:Human, Mouse,Rat
-
免疫原:Synthesized peptide derived from human LANCL1
-
免疫原種屬:Homo sapiens (Human)
-
克隆類型:Polyclonal
-
抗體亞型:IgG
-
純化方式:Antigen?affinity?purification
-
濃度:It differs from different batches. Please contact us to confirm it.
-
保存緩沖液:Liquid in PBS containing 50% glycerol, 0.5% BSA and 0.02% sodium azide.
-
產(chǎn)品提供形式:Liquid
-
應(yīng)用范圍:ELISA, WB, IHC
-
推薦稀釋比:
Application Recommended Dilution WB 1:1000-1:5000 IHC 1:200-1:500 -
Protocols:
-
儲存條件:Upon receipt, store at -20°C or -80°C. Avoid repeated freeze.
-
貨期:Basically, we can dispatch the products out in 1-3 working days after receiving your orders. Delivery time maybe differs from different purchasing way or location, please kindly consult your local distributors for specific delivery time.
-
用途:For Research Use Only. Not for use in diagnostic or therapeutic procedures.
相關(guān)產(chǎn)品
靶點詳情
-
功能:Functions as glutathione transferase. Catalyzes conjugation of the glutathione (GSH) to artificial substrates 1-chloro-2,4-dinitrobenzene (CDNB) and p-nitrophenyl acetate. Mitigates neuronal oxidative stress during normal postnatal development and in response to oxidative stresses probably through GSH antioxidant defense mechanism. May play a role in EPS8 signaling. Binds glutathione.
-
基因功能參考文獻:
- Lanthionine synthetase C-like protein 1 interacts with and inhibits cystathionine beta-synthase: a target for neuronal antioxidant defense. PMID: 22891245
- the crystal structures of human LanCL1, both free of and complexed with glutathione, revealing glutathione binding to a zinc ion at the putative active site formed by conserved GxxG motifs PMID: 19528316
-
亞細(xì)胞定位:Cytoplasm. Cell membrane; Peripheral membrane protein.
-
蛋白家族:LanC-like protein family
-
組織特異性:Detected in erythrocytes, brain, kidney, testis, ovary, heart, lung, placenta and spleen (at protein level). Ubiquitous. Strongly expressed in brain, spinal cord, pituitary gland, kidney, heart, skeletal muscle, pancreas, ovary and testis.
-
數(shù)據(jù)庫鏈接:
Most popular with customers
-
-
YWHAB Recombinant Monoclonal Antibody
Applications: ELISA, WB, IHC, IF, FC
Species Reactivity: Human, Mouse, Rat
-
-
-
-
-
-